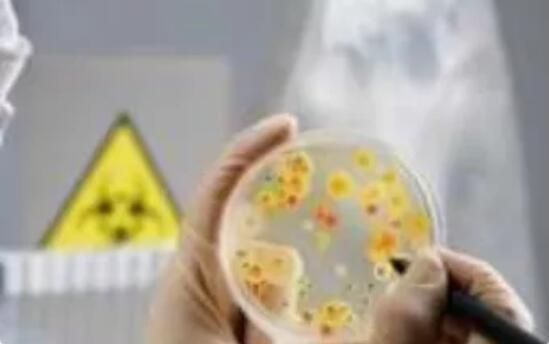
婴儿米粉怎么吃

[婴儿营养]婴儿米粉从4到6个月就开始吃了。因为米粉是婴儿最早可以添加的辅食,当婴儿身体状况较好时可以尝试添加婴儿米粉。婴儿在4到6个月的时候很容易出现生理性贫血,此时给婴儿吃含铁的米粉
米粉是宝宝经常接触到的辅食,在孩子的成长过程中起着重要的作用;冲不好,吃不对,不但营养跟不上,还会对孩子身体造成伤害!所以,可千万别小看冲米粉的问题,冲不对可能会出大问题!给宝宝冲米粉都应该要注意哪些事儿?
雷区1:用开水冲米粉
很多家长可能会觉得给宝宝冲米粉得用开水,每次给宝宝冲米粉,还得提前备好开水。

真相:水温太高,米粉营养易流失!
冲调米粉的水温太高,米粉中的营养容易流失;水温太低,米粉不溶解,混杂在一起会结块,小宝宝吃了会消化不良。
✔ 正确做法:
米粉用60℃左右的温水冲就可以,如果产品上有建议温度,就按说明来。
不要用开水,开水会破坏米粉中的营养物质。
雷区2:用奶冲米粉
有的妈妈会问,娃不喜欢纯米粉的味道,能直接用奶冲米粉么?

真相:需要看奶粉类别!
如果类别为「婴幼儿谷物辅助食品」,可以用温水或者温奶(母乳或配方奶)冲调;如果类别为「婴幼儿高蛋白谷物辅助食品」,应该用温水冲调。
那么,婴幼儿谷物辅助食品,应该怎么冲呢?这就需要根据家里宝宝的情况来调整了。
✔ 正确做法:
如果宝宝一开始吃米粉不习惯味道,用奶冲可以让宝宝更加容易接受米粉,而且,对于喝奶量少、或者生长缓慢的宝宝来说,可以增加奶的摄入量,增加营养摄入。但是,如果家里是个胖宝宝,或者平时喝奶已经很多了,还是用水冲比较好。
雷区3:用蔬菜汁、果汁冲米粉
经常看到很多婴儿食谱,会建议妈妈们把菜汁或果汁兑到米粉中给宝宝吃。
很多妈妈可能也会觉得,用水冲米粉没什么味道,加点果汁或者蔬菜汁既有味道又健康。

真相:破坏了原本的营养素,还可能中毒!
果汁中的主要成分是糖,小宝宝最好不要摄入太多糖。而蔬菜煮汁也不是特别推荐,我们要的是蔬菜里的营养素、维生素,这些营养素在加热过程中,破坏非常多。除了含糖高,营养素被破坏之外,用蔬菜汁冲米粉还可能导致亚硝酸盐中毒!(前面6个月宝宝就是一个例子)
雷区4:米粉越浓稠越好
有的家长在冲奶粉的时候怕宝宝吃不饱,会在原来的基础上再多加点米粉,把米粉冲调的稠稠的,觉得这样宝宝一下子就可以吃饱了。

真相:容易消化不良、减少奶量摄入!
宝宝的胃功能比较弱,米粉又比较浓稠,吃多了容易消化不良,还会减少奶的摄入,使宝宝营养不良。
✔ 正确做法:
一般说来,爸妈可以根据按照包装说明来控制水、粉比例,多试几次,自己可以微调米糊的浓度。
雷区5:自己做的米粉更好
很多爸妈担心食品安全问题,生怕外面买的米粉质量不过关,吃坏了宝宝。米粉嘛,顾名思义,米磨成粉就好了,家里也能做呀!
真相:市售米粉更安全卫生、营养成分更足!
与自制米粉相比,最大的优势在于额外添加了「铁」元素,能帮助辅食初期的宝宝预防和改善缺铁性贫血。有家长担心,市售的米粉含有「添加剂」,没有自制米粉天然、健康。
其实恰恰相反,符合国家标准的婴儿米粉对原料选择、制备环境、污染物和霉菌有明确的卫生要求。而家庭自制、以及各种手工作坊,很难保证这一点。
米粉中的「添加剂」,其实是对米粉进行了营养素的强化。把普通米粉在营养上短板的地方进行补充完善,对宝宝而言拥有更高的营养价值。
✔ 正确做法:
若宝宝对市售米粉产生不适,这时可以考虑自制米粉。如果给宝宝吃的是没有强化铁的纯米粉,就要注意给宝宝及时引入肉泥、肝泥等含铁丰富且吸收率高的食物。
避开了这些雷区,
我们就来看看应该怎么吃?
吃到什么时候好?什么样的米粉好?

米粉的摄入量没有官方推荐,随着宝宝摄入的谷类越来越丰富,米粉逐渐被日常的谷物所取代。
当然,添加辅食的初期要以米粉为主,米粉口感细腻、致敏性低同时强化了各种营养素,是宝宝初加谷类的最佳选择。
一开始给宝宝冲米粉一顿只有一小勺(大概3-5克),慢慢增加到10克、20克。
但最终吃多少还是取决于宝宝。如果宝宝嘴巴紧闭、用舌头把勺子顶出、东张西望等,则表示已经吃饱,妈妈则可以停止喂食。
✔ 喂米粉的正确姿势是这样的:
勺子平移到宝宝嘴边,待他张开嘴,用勺头伸进宝宝的嘴巴,让他自己用嘴唇抿下米糊。
宝宝需要自己学习怎样吃到勺子上的食物,这样能够锻炼宝宝的进食技巧。
等宝宝抿下米糊后,将勺子平移取出。
爸妈可以对照自查一下,下面几个动作是错误的哦:
✘ 在宝宝不想吃的时候,撬开嘴巴塞入食物;
✘ 米糊太稀,倒入宝宝嘴里;
✘ 米糊太稠,刮入宝宝嘴里;
✘ 勺子伸得太靠内,刺激到咽部,引起不适。

1. 富含高铁
7~12 月龄婴儿对铁的需要量,每天高达 8~10mg 。给宝宝吃的米粉,尽量挑选铁含量更高一些的。加微信1726076400免费咨询育儿问题
2. 成分简单
最好不要有糖、盐等对宝宝成长不利的成分。色素、防腐剂等添加剂这些对宝宝没啥用的东西,最好也没有!
3. 口感细腻易吸收
对于口感来说,当然要挑选更加细腻易吸收的产品,才能博得宝宝的喜欢。
宝宝的日常饮食需要细心安排,而米粉作为重要的 “成员” ,爸爸妈妈要细心选择,用心冲调,让宝宝远离伤害!
[婴儿营养]婴儿米粉从4到6个月就开始吃了。因为米粉是婴儿最早可以添加的辅食,当婴儿身体状况较好时可以尝试添加婴儿米粉。婴儿在4到6个月的时候很容易出现生理性贫血,此时给婴儿吃含铁的米粉
[婴儿营养]不是越久越好 。一旦宝宝能比较好的吃各种肉类,比如到了7-8月龄,婴儿配方米粉就可以随时被替换下来。 婴儿配方米粉经过铁强化,可以给宝宝提供额外的铁元素;同时因为它比较细腻,孩
[婴儿营养]米粉是宝宝常见的辅食一个,不是所有的父母都知道怎么给喂米粉,如果出现宝宝身体健康的话,会影响宝宝的,所以,父母时刻需要一些常见的喂米粉的误区。 粉粉在宝宝陪伴的时候,被加
[婴儿营养]宝宝的第一口辅食最好是口味清淡还有营养的婴儿米粉。很多人会觉得冲米粉太简单了!每天冲几次,闭着眼睛都会冲。但经过调查才发现很多人都是按自己的理解去做的,完全做对的人寥寥
[饮食常识]相较糯米,糯米粉的可塑性其实更高,制作起来也更简便。因其软软糯糯的特点,不仅可以用来做各种小吃、点心,还可以把它放到汤羹里,起到增稠,提升口感的作用,比如奶香南瓜羹。另
[婴儿营养]宝宝开始吃辅食后,就可以尝试吃鸡蛋了。 但我们不建议,鸡蛋作为宝宝的第一辅食。 因为,宝宝的第一口辅食应优先选择含铁丰富的食物如米粉、红肉泥等。蛋黄中铁含量虽然不低,但卵黄
[婴儿营养]不同程度贫血补铁方案:1、轻度缺铁性贫血,还是建议首选食疗来补铁,可以试试上述的饮食方案。2、中度缺铁性贫血,食疗的同时+口服铁剂。很多食物(比如牛奶),可能会导致铁的吸收
[婴儿营养]关于什么时候可以给宝宝添加辅食,一直是家长们都很关心的事。其实,每个宝宝生长发育的情况不同,添加辅食的时间也不相同。 1、怎么判断宝宝可以添加辅食了? 一般情况下,建议宝宝
[婴儿营养]给宝宝吃鱼肝油主要是为了帮助宝宝吸收钙,同时防止婴儿患有佝偻病,鱼肝油的主要成分是脂溶性维生素A和维生素D,缺乏维生素A会影响胎儿的骨骼和牙齿釉质细胞,导致夜盲症,引起呼吸
[婴儿营养]鸡蛋,辅食中的「种子选手」,营养价值往往能受到家里「老、中、青」三代人的高度好评,拥有非常广泛的群众基础。 育儿观念分歧再大的家庭,在「吃鸡蛋好」这件事上总是可以达到高度